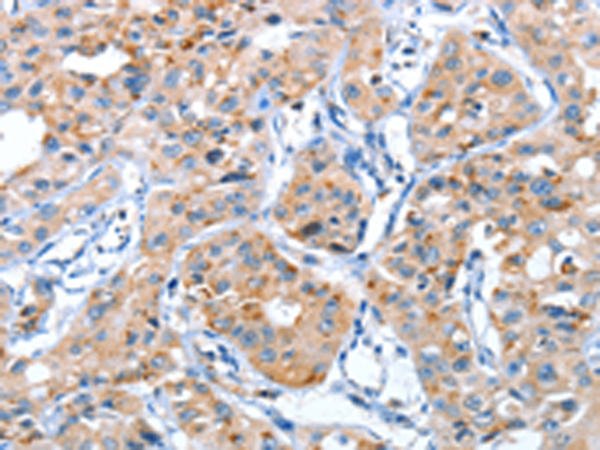
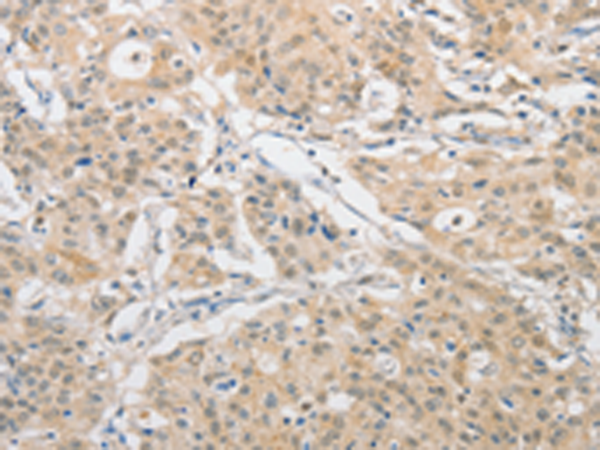

-
分类: 科研抗体货号: P07867别名: G3a; NG20; apo-M; HSPC336应用: WB反应种属: Human, Mouse, Rat
-
分类: 科研抗体货号: P07845别名: LCCP应用: IHC反应种属: Human, Mouse, Rat
-
分类: 科研抗体货号: P07828别名: CRYA2; CTPP2; HSPB5; CMD1II应用: WB,IHC反应种属: Human, Mouse, Rat
-
分类: 科研抗体货号: P07866别名:应用: WB反应种属: Human
-
分类: 科研抗体货号: P07844别名:应用: WB,IHC反应种属: Human, Mouse, Rat
-
分类: 科研抗体货号: P07826别名: AHS; A2HS; HSGA; FETUA应用: WB,IHC反应种属: Human
-
分类: 科研抗体货号: P07864别名: APFL; PALF; Xip1; C2orf13应用: IHC反应种属: Human
-
分类: 科研抗体货号: P07843别名: AMSH应用: IHC反应种属: Human, Mouse, Rat
-
分类: 科研抗体货号: P07854别名: mu2; AP50; CLAPM1应用: IHC反应种属: Human, Mouse, Rat
-
分类: 科研抗体货号: P07861别名: APG3; APG3L; PC3-96; APG3-LIKE应用: WB,IHC反应种属: Human, Mouse, Rat

鄂公网安备42018502007531号
鄂公网安备42018502007531号

